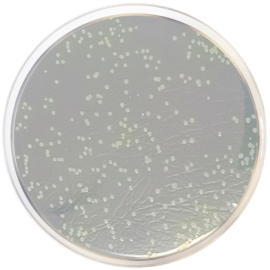
main product photo

Close
NUTRIENT AGAR (UNE-EN 12780) 500 grams/bottle
SKU
CDL/1156
Brand
CONDALAB
Pre-order (Deliver in 8 to 12 weeks)
Nutirent Agar is a medium used to obtain a pure culture for the confirmation of the presumptive positive colonies obtained in Pseudomonas CN Agar Base (Cat. 1153).
Pseudomonas aeruginosa is an opportunist pathogen for humans, capable of growing in water with a low concentration of nutrients. This is why natural mineral water and spring water are Pseudomonas aeruginosa free at the time of their commercialization. This microorganism can also be found in swimming pool water.
Peptone and beef extracts provide the nitrogen, vitamins, minerals and amino acids nutrient source. Yeast extract is a vitamins source, particularly of the B-group, essential for bacterial growth. Sodium chloride maintains the osmotic balance and the bacteriological agar is the solidifying agent.
Nutirent Agar is a medium used to obtain a pure culture for the confirmation of the presumptive positive colonies obtained in Pseudomonas CN Agar Base (Cat. 1153).
Pseudomonas aeruginosa is an opportunist pathogen for humans, capable of growing in water with a low concentration of nutrients. This is why natural mineral water and spring water are Pseudomonas aeruginosa free at the time of their commercialization. This microorganism can also be found in swimming pool water.
Peptone and beef extracts provide the nitrogen, vitamins, minerals and amino acids nutrient source. Yeast extract is a vitamins source, particularly of the B-group, essential for bacterial growth. Sodium chloride maintains the osmotic balance and the bacteriological agar is the solidifying agent.
| Brand | CONDALAB |
|---|
Write Your Own Review

Validate your login